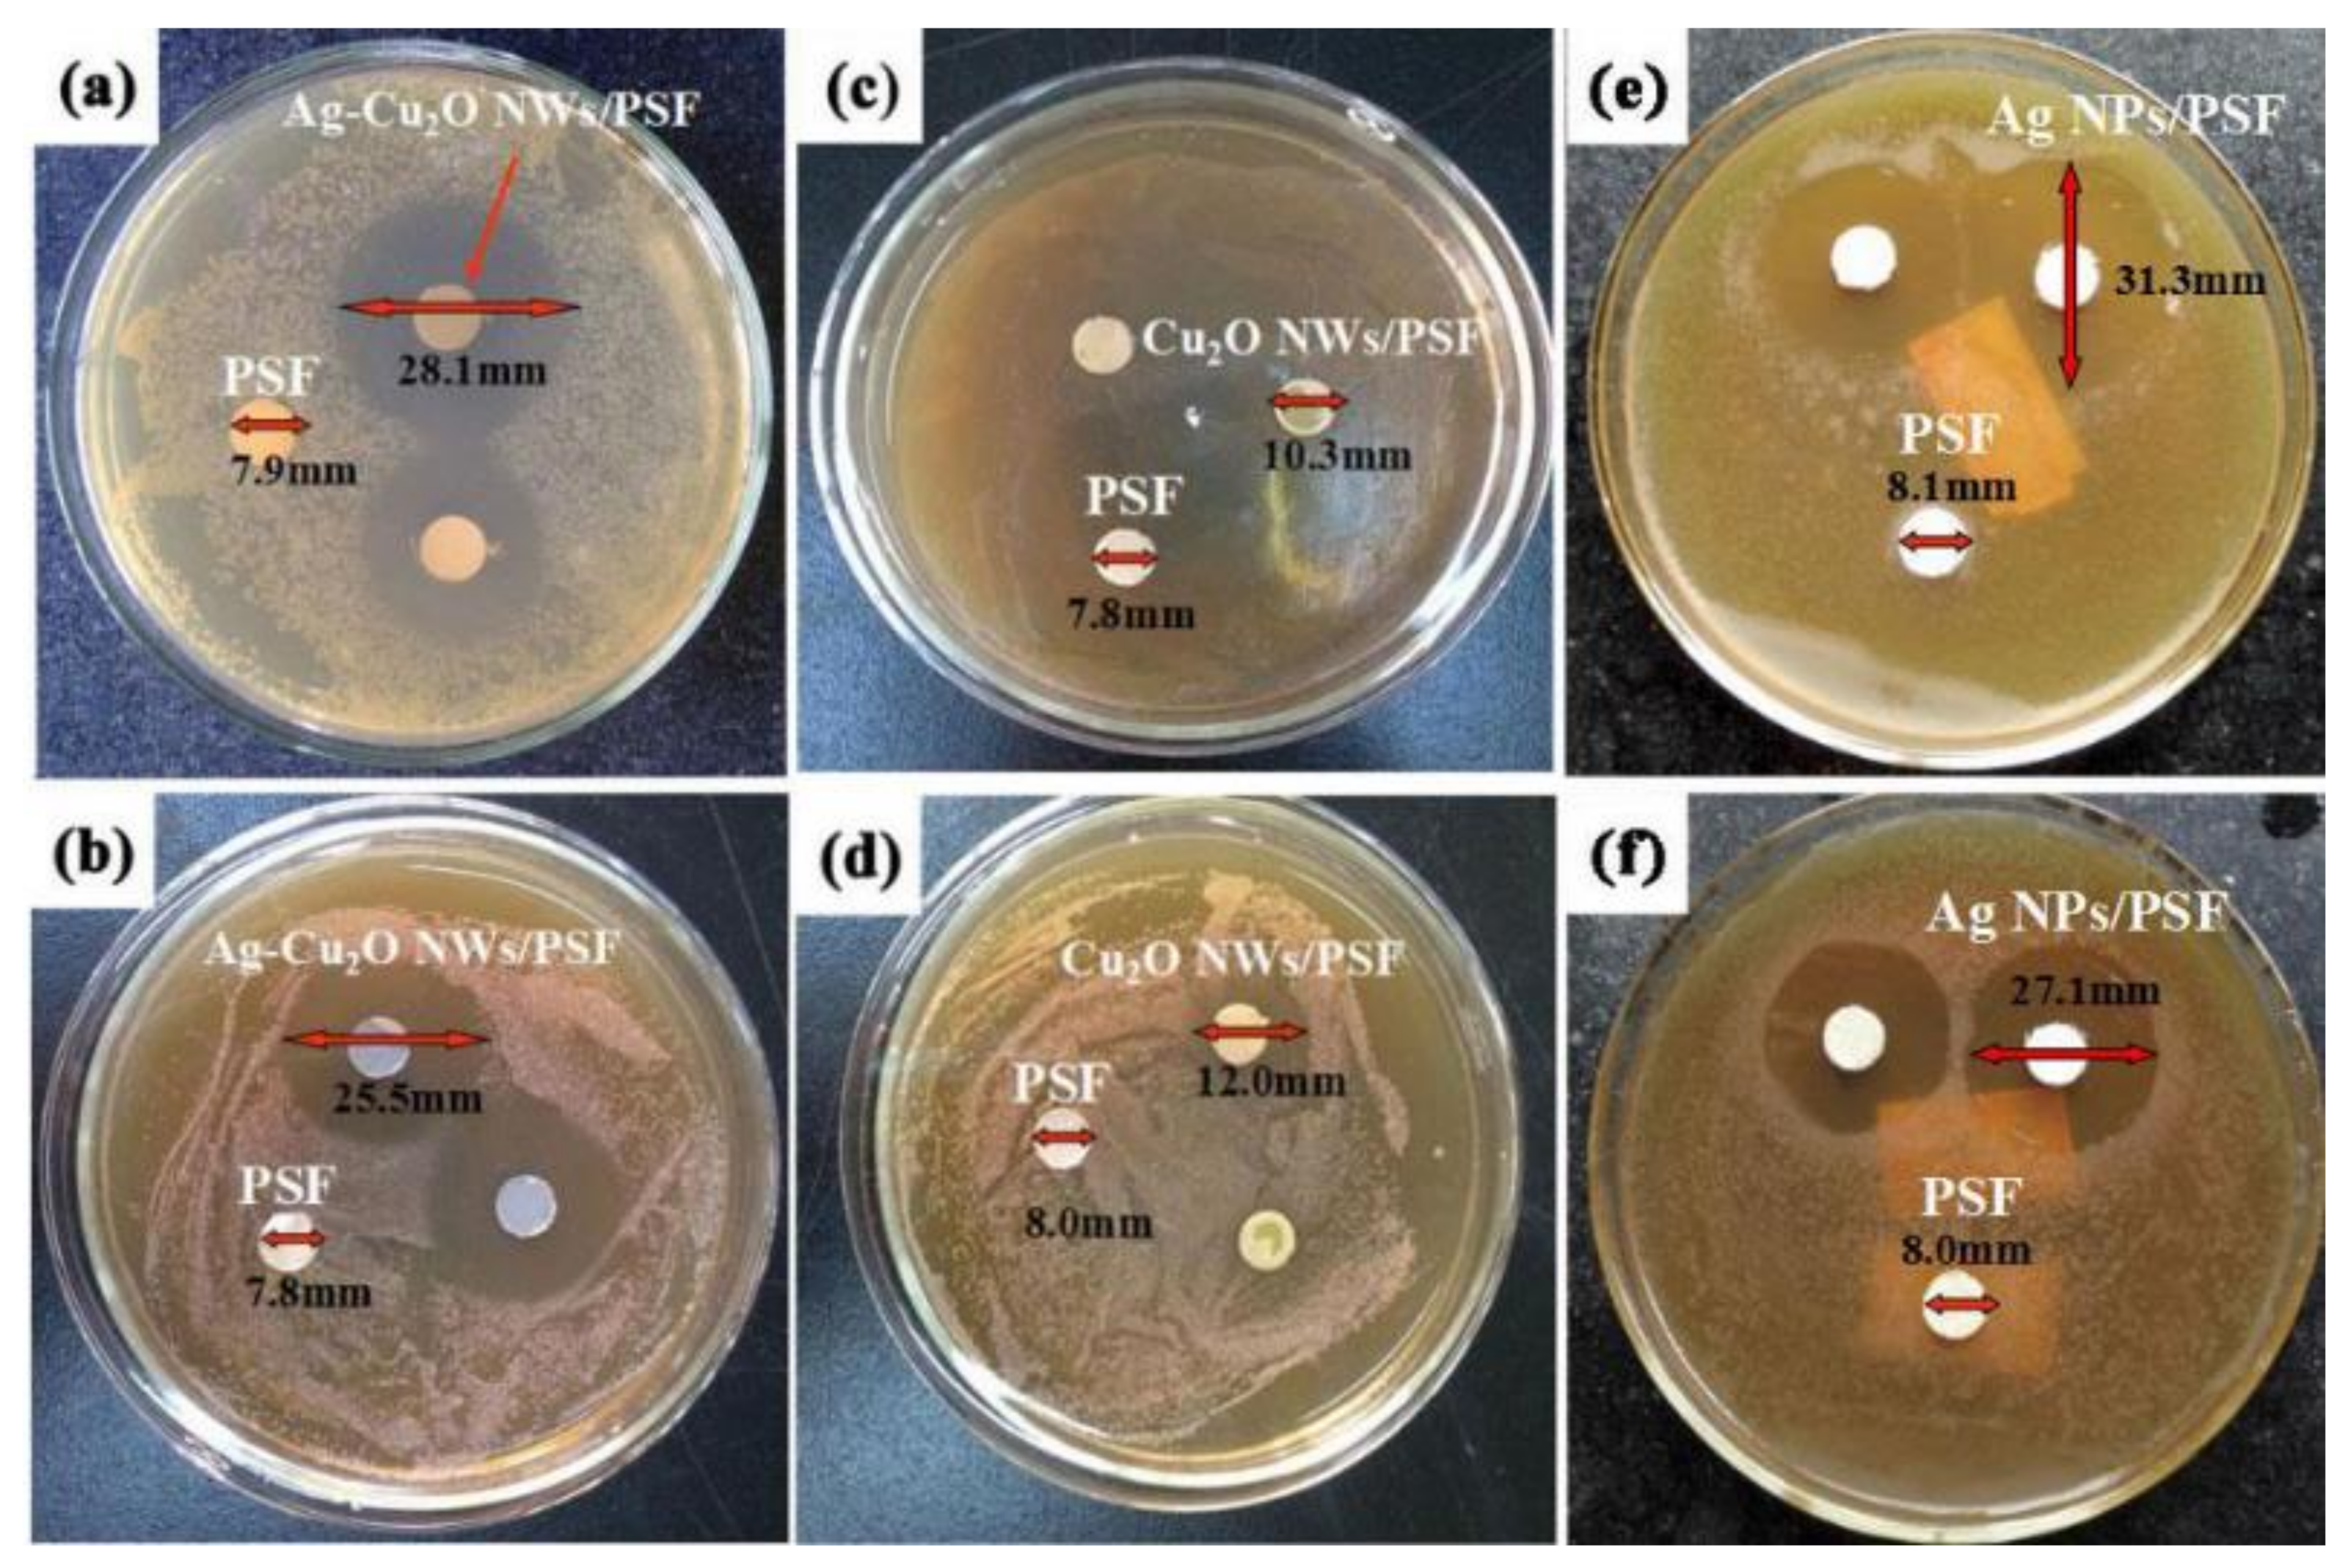
Membranes 12 01043 g012

Classification of Nanomaterials and the Effect of Graphene Oxide (GO) and Recently Developed Nanoparticles on the Ultrafiltration Membrane and Their Applications: A Review
Abstract
1. Introduction
2. Mixed Matrix Membranes (MMM)
2.1. Classification of Nanomaterials
2.1.1. Mineral Nanomaterials
SiO2
Zeolite
2.1.2. Metal Oxides
CuO
ZrO2
ZnO
ATO
Fe2O3
Tungsten Oxide (WOx)
2.1.3. Two-Dimensional Transition Metal
2.1.4. Metal–Organic Frameworks (MOFs)
2.1.5. Covalent Organic Frameworks (COFs)
| Type of Polymer | Type and Composition of NPs | %Porosity | Pore Size (nm) | Contact Angle | Flux (L/m2·h) | Mean Roughness (nm) | %Rejection | Ref. |
|---|---|---|---|---|---|---|---|---|
| PSf | ZnO-GO 0.6% | 90% | 4.09 | 39.6° | 4.03 | 99% humic acid | [63] | |
| PES | 0.1 wt% ZnO | 47.34% | 13.96 | 60.9° | 80 kg/m2·h | 24.74 | 94% humic acid | [20] |
| PVC | 3 wt% ZnO | 79.8% | 12.1 | 54.5° | 401.9 kg/m2·h | 97.5% BSA | [74] | |
| PPSU | (0.025) ZnO/MWCNTs | 120.43 | 57.5° | 2 | 98.57% Direct red 80 | [75] | ||
| PES | ZrO2 (1% wt) | 52.3° | 83.6 L/m2·h | 13.8 | 92.7% BSA 91.2% OVA | [70] | ||
| PES | TiO2/F127 | 91.3% | 22.09 | 61.2° | 235.9 L/m2·h | 4.24 | 96% BSA | [92] |
| PES | CuO/ZnO (0.2%) | 39.76 | 65.5° | 679 kg/m2·h | 8.19 | 99% BSA | [18] | |
| PES | CuO (0.1%wt) | 16.7 | 64° | 869.9 kg/m2·h | 1.34 | 97% BSA | [23] | |
| PPSU | 2 wt% BiOCl-AC | 72.99% | 67.40° | 465.35 L/m2·h | 80% diesel fuel & 90.74% crude oil | [93] | ||
| PVC | TiO2(1.5 gm) | 79.5% | 77 | 62.5° | 116 L/m2·h | 96.3% oil and grease 79.7% COD 98.8% TSS | [11] | |
| PVDF | TiO2 (<2 wt.%) | 47.3 | 76° | 111.7 L/m2·h | 100% BSA | [94] | ||
| EPVC/PEG | TiO2 (2 wt.%) | 78.7% | 25 | 57.2° | 435 kg/m2·h | 98% BSA | [95] | |
| PES/PVP | Ni@MXene (1 gm) | 54.15° | 1181 L·m−2·h−1·bar−1 | 24.3 | 64.6% BSA solution 99.8% HA solution | [61] | ||
| PSF/PVP | MXene nanosheets (500 mg/L) | 74.4% | 36 | 78.4° | 306 L·m−2·h−1 | 15.5 | 98% BSA rejection | [82] |
| PES | MOFs@GO (UIO-66@GO) 3.0 wt.% | 60.4° | 15.5~kg/m2·h | 11.8 | 98.3% dye rejection | [88] | ||
| PSF | Tp-TTA/mPSFx COFs 10% | 1.6 | 42°~ | 36.52 L m−2 h−1 bar−1 | 98.18% CB-T rejection | [91] | ||
| 14%PES/2%PVP | ATO 4 wt.% | 9.2 | 47° | 22–15 L·m−2·h−1 | 75% separation of organic matter from the BFW | [76] | ||
| PES/PVP | NaX-Zeolite(0.9 wt.%) | 45.5% | 63° | 88.05 L·m−2·h−1 | 97% Pb(II) removal | [25] | ||
| PES/PVP | NaY zeolite(0.15 wt.%) | 73.6% | 27.68 | 97.8 L·m−2·h−1 | 99.2% removing 137 Cs ions from a liquid radioactive sample | [67] | ||
| PES | 5% PTGM | 81.21% | 54.91 | 203.1 L·m−2·h−1 | 93.8% BSA 95.6% SA | [96] | ||
| PES/PEI | (0.7 wt.%) SiO2 | 19.11 | 39.7 L·m−2·h−1 43.3 L·m−2·h−1 | 14.7 | 94.1% Congo red dye 90.5% reactive black dye | [66] | ||
| PPSU | 0.15%Gum Arabic-Graphen | 95.57 | 82.11 L·m−2·h−1 | 88% sodium alginate | [97] |
2.1.6. Carbon-Based Nanomaterials
GO
- Pure GO additives
- Hyper-GO into polymeric membrane
Carbon Nanotubes (CNTs) and Nanofibers (CNFs)
3. Effect of NPs on the Morphology of the PPSU, PES and PVC Membranes
4. Application of MMMs

5. Conclusions and Future Prospects
- The addition of GO may make the membrane more adsorbent and have good anti-fouling properties by increasing the membrane hydrophilic character. This is attributed to GOs’ characteristics, which include a large surface area and assessable adsorption sites, higher hydrophilic properties and selective site.
- ZnO is used in photocatalytic membranes for organic pollutants in water because of its photocatalytic activity, stability, selectivity and low cost. It could also be used with membranes in medical application due to the antimicrobial properties that have been added to various polymers since it has been confirmed to be useful in the treatment of bacterial infections. The same is true of Ag, TiO2 and CuO, which are also used with polymeric membrane in the medical sector.
- Ag, Ni and Zr are employed in membranes for the separation of gases. For example, ceramic dense membranes are used in the separation of oxygen from air or even the separation of hydrogen from a mixture of gases. The low permeability limits their industrial applications.
- WOx mixed with membranes has been widely used, especially in recent years, because of its special properties: photocatalytic application and antimicrobial use. This has become one of the most studied metal oxides.
- Because of the efficiencies seen and the advantages of MOFs, COFs, MXene nanoparticles, researchers have paid considerable attention to mixing them with polymeric membranes and this research has grown rapidly in recent years.
- MXene/polymer membranes have been presented and shown great promise, with an overall performance superior to neat polymer films.
- COF materials with ordered channels and functionalized groups inside the channels provide a new strategy for achieving high performance in the advancement of membrane processes for separation.
- MOFs, compared to the ordinary inorganic particles with ‘rigid’ frameworks, have a unique nature that may support growing with the polymer, allowing for good compatibility.
Author Contributions
Funding
Institutional Review Board Statement
Informed Consent Statement
Data Availability Statement
Acknowledgments
Conflicts of Interest
References
- Makki, Z.F.; Zuhaira, A.A.; Al-Jubouri, S.M.; Al-Hamd, R.K.S.; Cunningham, L.S. GIS-based assessment of groundwater quality for drinking and irrigation purposes in central Iraq. Environ. Monit. Assess. 2021, 193, 107. [Google Scholar] [CrossRef] [PubMed]
- Alkhouzaam, A.; Qiblawey, H. Novel polysulfone ultrafiltration membranes incorporating polydopamine functionalized graphene oxide with enhanced flux and fouling resistance. J. Memb. Sci. 2021, 620, 118900. [Google Scholar] [CrossRef]
- Li, Y.Y.; Lin, L.; Li, X.Y. Chemically enhanced primary sedimentation and acidogenesis of organics in sludge for enhanced nitrogen removal in wastewater treatment. J. Clean. Prod. 2020, 244, 118705. [Google Scholar] [CrossRef]
- Ødegaard, H. The use of dissolved air flotation in municipal wastewater treatment. Water Sci. Technol. 2001, 43, 75–81. [Google Scholar] [CrossRef]
- Ali, H.Q.; Mohammed, A.A. Elimination of Congo Red Dyes From Aqueous Solution Using Eichhornia Crassipes. Iraqi J. Chem. Pet. Eng. 2020, 21, 21–32. [Google Scholar] [CrossRef]
- Alhassani, M.h.; Al-Jubouri, S.; Al-Jendeel, H.A. Stabilization of phenol trapped by agricultural waste: A study of the influence of ambient temperature on the adsorbed phenol. Desalin. Water Treat. 2020, 187, 266–276. [Google Scholar] [CrossRef]
- De Haro-Del Rio, D.A.; Al-Jubouri, S.M.; Holmes, S.M. Hierarchical porous structured zeolite composite for removal of ionic contaminants from waste streams. Chim. Oggi-Chem. Today 2017, 35, 26–29. [Google Scholar]
- Al-Rahmani, A.A.; Al-Attafi, S.K.; Al-Nasri, S.K.; Jasim, Z.W. Hierarchical Structures Incorporating Carbon and Zeolite to Remove Radioactive Contamination. Iraqi J. Sci. 2020, 61, 1944–1951. [Google Scholar] [CrossRef]
- Hadi, S.; Mohammed, A.A.; Al-Jubouri, S.M.; Abd, M.F.; Majdi, H.S.; Alsalhy, Q.F.; Rashid, K.T.; Ibrahim, S.S.; Salih, I.K.; Figoli, A. Experimental and Theoretical Analysis of Lead Pb2+ and Cd2+ Retention from a Single Salt Using a Hollow Fiber PES Membrane. Membranes 2020, 10, 136. [Google Scholar] [CrossRef]
- Ahmed, S.H.; Al-Jubouri, S.M.; Zouli, N.; Mohammed, A.A.; Majdi, H.S.; Salih, I.K.; Al-Shaeli, M.; Al-Rahawi, A.M.I.; Alsalhy, Q.F.; Figoli, A. Performance Evaluation of Polyethersulfone Membranes for Competitive Removal of Cd2+, Co2+, and Pb2+Ions from Simulated Groundwater. Geofluids 2021, 2021, 6654477. [Google Scholar] [CrossRef]
- Al-Ani, F.H.; Alsalhy, Q.F.; Raheem, R.S.; Rashid, K.T.; Figoli, A. Experimental investigation of the effect of implanting tio2-nps on pvc for long-term uf membrane performance to treat refinery wastewater. Membranes 2020, 10, 77. [Google Scholar] [CrossRef] [PubMed]
- Celik, E.; Park, H.; Choi, H.; Choi, H. Carbon nanotube blended polyethersulfone membranes for fouling control in water treatment. Water Res. 2011, 45, 274–282. [Google Scholar] [CrossRef] [PubMed]
- Al-Ameri, M.K.; Al-Alawy, A.F. Ultrafiltration of Simulated Oily Wastewater Using the Method of Taguchi. Int. J. Sci. Eng. Res. 2016, 7, 503–508. [Google Scholar]
- Rashidi, H.R.; Sulaiman, N.M.N.; Hashim, N.A. Batik Industry Synthetic Wastewater Treatment Using Nanofiltration Membrane. Procedia Eng. 2012, 44, 2010–2012. [Google Scholar] [CrossRef]
- Liu, T.Y.; Liu, Z.H.; Zhang, R.X.; Wang, Y.; Van der Bruggen, B.; Wang, X.L. Fabrication of a thin film nanocomposite hollow fiber nanofiltration membrane for wastewater treatment. J. Memb. Sci. 2015, 488, 92–102. [Google Scholar] [CrossRef]
- Jiang, S.; Li, Y.; Ladewig, B.P. A review of reverse osmosis membrane fouling and control strategies. Sci. Total Environ. 2017, 595, 567–583. [Google Scholar] [CrossRef] [PubMed]
- Tran, T.; Bolto, B.; Gray, S.; Hoang, M.; Ostarcevic, E. An autopsy study of a fouled reverse osmosis membrane element used in a brackish water treatment plant. Water Res. 2007, 41, 3915–3923. [Google Scholar] [CrossRef] [PubMed]
- Nasrollahi, N.; Vatanpour, V.; Aber, S.; Mahmoodi, N.M. Preparation and characterization of a novel polyethersulfone (PES) ultrafiltration membrane modified with a CuO/ZnO nanocomposite to improve permeability and antifouling properties. Sep. Purif. Technol. 2018, 192, 369–382. [Google Scholar] [CrossRef]
- Mahlangu, O.T.; Nackaerts, R.; Mamba, B.B.; Verliefde, A.R.D. Development of hydrophilic GO-ZnO/PES membranes for treatment of pharmaceutical wastewater. Water Sci. Technol. 2017, 76, 501–514. [Google Scholar] [CrossRef] [PubMed]
- Ahmad, A.L.; Sugumaran, J.; Shoparwe, N.F. Antifouling properties of PES membranes by blending with ZnO nanoparticles and NMP-acetone mixture as solvent. Membranes 2018, 8, 131. [Google Scholar] [CrossRef]
- Nasrollahi, N.; Vatanpour, V.; Aber, S. Improving the permeability and antifouling property of PES ultrafiltration membranes using the drying method and incorporating the CuO-ZnO nanocomposite. J. Water Process Eng. 2019, 31, 100891. [Google Scholar] [CrossRef]
- Mahlangu, O.T.; Nackaerts, R.; Thwala, J.M.; Mamba, B.B.; Verliefde, A.R.D. Hydrophilic fouling-resistant GO-ZnO/PES membranes for wastewater reclamation. J. Memb. Sci. 2017, 524, 43–55. [Google Scholar] [CrossRef]
- Nasrollahi, N.; Aber, S.; Vatanpour, V.; Mahmoodi, N.M. Development of hydrophilic microporous PES ultrafiltration membrane containing CuO nanoparticles with improved antifouling and separation performance. Mater. Chem. Phys. 2019, 222, 338–350. [Google Scholar] [CrossRef]
- Abdullah, M.; Al-Jubouri, S. Implementation of hierarchically porous zeolite-polymer membrane for Chromium ions removal. IOP Conf. Ser. Earth Environ. Sci. 2021, 779, 012099. [Google Scholar] [CrossRef]
- Alfalahy, H.N.; Al-Jubouri, S.M. Preparation and application of polyethersulfone ultrafiltration membrane incorporating NaX zeolite for lead ions removal from aqueous solutions. Desalin. Water Treat. 2022, 3, 28–56. [Google Scholar] [CrossRef]
- Kadhim, R.J.; Al-Ani, F.H.; Alsalhy, Q.F. MCM-41 mesoporous modified polyethersulfone nanofiltration membranes and their prospects for dyes removal. Int. J. Environ. Anal. Chem. 2021, 1–21. [Google Scholar] [CrossRef]
- Aljumaily, M.M.; Alsaadi, M.A.; Hashim, N.A.; Alsalhy, Q.F.; Mjalli, F.S.; Atieh, M.A.; Al-Harrasi, A. PVDF-co-HFP/superhydrophobic acetylene-based nanocarbon hybrid membrane for seawater desalination via DCMD. Chem. Eng. Res. Des. 2018, 138, 248–259. [Google Scholar] [CrossRef]
- Zhang, D.; Dai, F.; Zhang, P.; An, Z.; Zhao, Y.; Chen, L. The photodegradation of methylene blue in water with PVDF/GO/ZnO composite membrane. Mater. Sci. Eng. C 2019, 96, 684–692. [Google Scholar] [CrossRef]
- Ayyaru, S.; Dinh, T.T.L.; Ahn, Y.H. Enhanced antifouling performance of PVDF ultrafiltration membrane by blending zinc oxide with support of graphene oxide nanoparticle. Chemosphere 2020, 241, 125068. [Google Scholar] [CrossRef] [PubMed]
- Kadhim, R.J.; Al-Ani, F.H.; Al-Shaeli, M.; Alsalhy, Q.F.; Figoli, A. Removal of dyes using graphene oxide (Go) mixed matrix membranes. Membranes 2020, 10, 366. [Google Scholar] [CrossRef] [PubMed]
- Liu, Y.; Xu, C.; Xie, B.; Hu, W.; Li, Y.; Yao, C. PAN ultrafiltration membranes grafted with natural amino acids for improving antifouling property. J. Coatings Technol. Res. 2018, 15, 403–414. [Google Scholar] [CrossRef]
- Dastbaz, Z.; Pakizeh, M.; Namvar-Mahboub, M. The effect of functionalized MWCNT and SDS on the characteristic and performance of PAN ultrafiltration membrane. Desalin. Water Treat. 2016, 57, 24267–24277. [Google Scholar] [CrossRef]
- Zhang, G.; Yan, H.; Ji, S.; Liu, Z. Self-assembly of polyelectrolyte multilayer pervaporation membranes by a dynamic layer-by-layer technique on a hydrolyzed polyacrylonitrile ultrafiltration membrane. J. Memb. Sci. 2007, 292, 1–8. [Google Scholar] [CrossRef]
- Feng, Y.; Lin, X.; Li, H.; He, L.; Sridhar, T.; Suresh, A.K.; Bellare, J.; Wang, H. Synthesis and characterization of chitosan-grafted BPPO ultrafiltration composite membranes with enhanced antifouling and antibacterial properties. Ind. Eng. Chem. Res. 2014, 53, 14974–14981. [Google Scholar] [CrossRef]
- Gao, L.; Tang, B.; Wu, P. An experimental investigation of evaporation time and the relative humidity on a novel positively charged ultrafiltration membrane via dry-wet phase inversion. J. Memb. Sci. 2009, 326, 168–177. [Google Scholar] [CrossRef]
- Alsalhy, Q.F.; Al-Ani, F.H.; Al-Najar, A.E. A new Sponge-GAC-Sponge membrane module for submerged membrane bioreactor use in hospital wastewater treatment. Biochem. Eng. J. 2018, 133, 130–139. [Google Scholar] [CrossRef]
- Sadiq, A.J.; Awad, E.S.; Shabeeb, K.M.; Khalil, B.I.; Al-Jubouri, S.M.; Sabirova, T.M.; Tretyakova, N.A.; Majdi, H.S.; Alsalhy, Q.F.; Braihi, A.J. Comparative study of embedded functionalised MWCNTs and GO in Ultrafiltration (UF) PVC membrane: Interaction mechanisms and performance. Int. J. Environ. Anal. Chem. 2020, 1–22. [Google Scholar] [CrossRef]
- Fadhil, S.; Marino, T.; Makki, H.F.; Alsalhy, Q.F.; Blefari, S.; Macedonio, F.; Di Nicolò, E.; Giorno, L.; Drioli, E.; Figoli, A. Novel PVDF-HFP flat sheet membranes prepared by triethyl phosphate (TEP) solvent for direct contact membrane distillation. Chem. Eng. Process. Process Intensif. 2016, 102, 16–26. [Google Scholar] [CrossRef]
- Zhao, C.; Xue, J.; Ran, F.; Sun, S. Modification of polyethersulfone membranes—A review of methods. Prog. Mater. Sci. 2013, 58, 76–150. [Google Scholar] [CrossRef]
- van der Bruggen, B. Chemical modification of polyethersulfone nanofiltration membranes: A review. J. Appl. Polym. Sci. 2009, 114, 630–642. [Google Scholar] [CrossRef]
- Balta, S.; Sotto, A.; Luis, P.; Benea, L.; Van der Bruggen, B.; Kim, J. A new outlook on membrane enhancement with nanoparticles: The alternative of ZnO. J. Memb. Sci. 2012, 389, 155–161. [Google Scholar] [CrossRef]
- Escobar, I.C.; Van der Bruggen, B. Microfiltration and ultrafiltration membrane science and technology. J. Appl. Polym. Sci. 2015, 132, 8–22. [Google Scholar] [CrossRef]
- Listiarini, K.; Chun, W.; Sun, D.D.; Leckie, J.O. Fouling mechanism and resistance analyses of systems containing sodium alginate, calcium, alum and their combination in dead-end fouling of nanofiltration membranes. J. Membr. Sci. 2009, 344, 244–251. [Google Scholar] [CrossRef]
- Liderfelt, J.; Royce, J. Filtration Principles. In Biopharmaceutical Processing; Elsevier Ltd.: Amsterdam, The Netherlands, 2018; pp. 279–293. [Google Scholar] [CrossRef]
- Kucera, J. Biofouling of Polyamide Membranes: Fouling Mechanisms, Current Mitigation and Cleaning Strategies, and Future Prospects. Membranes 2019, 9, 111. [Google Scholar] [CrossRef] [PubMed]
- Maiti, A.; Sadrezadeh, M.; Thakurta, S.G.; Pernitsky, D.J.; Bhattacharjee, S. Characterization of Boiler Blowdown Water from Steam-Assisted Gravity Drainage and Silica–Organic Coprecipitation during Acidification and Ultrafiltration. Energy Fuels 2012, 26, 5604–5612. [Google Scholar] [CrossRef]
- Abdel-Karim, A.; Leaper, S.; Alberto, M.; Vijayaraghavan, A.; Fan, X.; Holmes, S.M.; Souaya, E.R.; Badawy, M.I.; Gorgojo, P. High flux and fouling resistant flat sheet polyethersulfone membranes incorporated with graphene oxide for ultrafiltration applications. Chem. Eng. J. 2018, 334, 789–799. [Google Scholar] [CrossRef]
- Sadiq, A.J.; Shabeeb, K.M.; Khalil, B.I.; Alsalhy, Q.F. Effect of embedding MWCNT-g-GO with PVC on the performance of PVC membranes for oily wastewater treatment. Chem. Eng. Commun. 2019, 207, 733–750. [Google Scholar] [CrossRef]
- Maroofi, S.M.; Mahmoodi, N.M. Zeolitic imidazolate framework-polyvinylpyrrolidone-polyethersulfone composites membranes: From synthesis to the detailed pollutant removal from wastewater using cross flow system. Colloids Surfaces A: Physicochem. Eng. Asp. 2019, 572, 211–220. [Google Scholar] [CrossRef]
- Yanwachiragul, W.; Lohwacharin, J.; Sajomsang, W.; Singto, S. Removal of fluoride ions from groundwater using surface-modified ultrafiltration membrane. IOP Conf. Series: Mater. Sci. Eng. 2020, 773, 012007. [Google Scholar] [CrossRef]
- Yurekli, Y. Removal of heavy metals in wastewater by using zeolite nano-particles impregnated polysulfone membranes. J. Hazard. Mater. 2016, 309, 53–64. [Google Scholar] [CrossRef] [PubMed]
- Garcia-Ivars, J.; Alcaina-Miranda, M.I.; Iborra-Clar, M.I.; Mendoza-Roca, J.-A.; Pastor-Alcañiz, L. Enhancement in hydrophilicity of different polymer phase-inversion ultrafiltration membranes by introducing PEG/Al2O3 nanoparticles. Sep. Purif. Technol. 2014, 128, 45–57. [Google Scholar] [CrossRef]
- Rameetse, M.S.; Aberefa, O.; Daramola, M.O. Effect of Loading and Functionalization of Carbon Nanotube on the Performance of Blended Polysulfone/Polyethersulfone Membrane during Treatment of Wastewater Containing Phenol and Benzene. Membranes 2020, 10, 54. [Google Scholar] [CrossRef] [PubMed]
- Abu-Dalo, M.A.; Al-Atoom, M.A.; Aljarrah, M.T.; Albiss, B.A. Preparation and Characterization of Polymer Membranes Impregnated with Carbon Nanotubes for Olive Mill Wastewater. Polymers 2022, 14, 457. [Google Scholar] [CrossRef] [PubMed]
- Muhamad, M.S.; Salim, M.R.; Lau, W.-J. Preparation and characterization of PES/SiO2 composite ultrafiltration membrane for advanced water treatment. Korean J. Chem. Eng. 2015, 32, 2319–2329. [Google Scholar] [CrossRef]
- Sun, Z.; Chen, H.; Ren, X.; Zhang, Z.; Guo, L.; Zhang, F.; Cheng, H. Preparation and application of zinc oxide poly (m-phenylene isophthalamide) hybrid ultrafiltration membranes. J. Appl. Polym. Sci. 2019, 136, 47583. [Google Scholar] [CrossRef]
- Abdullah, R.R.; Shabeed, K.M.; Alzubaydi, A.B.; Alsalhy, Q.F. Novel photocatalytic polyether sulphone ultrafiltration (UF) membrane reinforced with oxygen-deficient Tungsten Oxide (WO2.89) for Congo red dye removal. Chem. Eng. Res. Des. 2022, 177, 526–540. [Google Scholar] [CrossRef]
- Han, R.; Ma, X.; Xie, Y.; Teng, D.; Zhang, S. Preparation of a new 2D MXene/PES composite membrane with excellent hydrophilicity and high flux. RSC Adv. 2017, 7, 56204–56210. [Google Scholar] [CrossRef]
- Huang, Z.; Zeng, Q.; Liu, Y.; Xu, Y.; Li, R.; Hong, H.; Shen, L.; Lin, H. Facile synthesis of 2D TiO2@MXene composite membrane with enhanced separation and antifouling performance. J. Membr. Sci. 2021, 640, 119854. [Google Scholar] [CrossRef]
- Kotobuki, M.; Gu, Q.; Zhang, L.; Wang, J. Ceramic-Polymer Composite Membranes for Water and Wastewater Treatment: Bridging the Big Gap between Ceramics and Polymers. Molecules 2021, 26, 3331. [Google Scholar] [CrossRef]
- Huang, Z.; Liu, J.; Liu, Y.; Xu, Y.; Li, R.; Hong, H.; Shen, L.; Lin, H.; Liao, B.-Q. Enhanced permeability and antifouling performance of polyether sulfone (PES) membrane via elevating magnetic Ni@MXene nanoparticles to upper layer in phase inversion process. J. Membr. Sci. 2021, 623, 119080. [Google Scholar] [CrossRef]
- Sun, D.; Yue, D.; Li, B.; Zheng, Z.; Meng, X. Preparation and performance of the novel PVDF ultrafiltration membranes blending with PVA modified SiO2 hydrophilic nanoparticles. Polym. Eng. Sci. 2018, 59, E412–E421. [Google Scholar] [CrossRef]
- Chung, Y.T.; Mahmoudi, E.; Mohammad, A.W.; Benamor, A.; Johnson, D.; Hilal, N. Development of polysulfone-nanohybrid membranes using ZnO-GO composite for enhanced antifouling and antibacterial control. Desalination 2017, 402, 123–132. [Google Scholar] [CrossRef]
- Liao, C.; Zhao, J.; Yu, P.; Tong, H.; Luo, Y. Synthesis and characterization of low content of different SiO2 materials composite poly (vinylidene fluoride) ultrafiltration membranes. Desalination 2012, 285, 117–122. [Google Scholar] [CrossRef]
- Vatanpour, V.; Shahsavarifar, S.; Khorshidi, S.; Masteri-Farahani, M. A novel antifouling ultrafiltration membranes prepared from percarboxylic acid functionalized SiO 2 bound Fe 3 O 4 nanoparticle (SCMNP-COOOH)/polyethersulfone nanocomposite for BSA separation and dye removal. J. Chem. Technol. Biotechnol. 2019, 94, 1341–1353. [Google Scholar] [CrossRef]
- Al-Araji, D.D.; Al-Ani, F.H.; Alsalhy, Q.F. Modification of polyethersulfone membranes by Polyethyleneimine (PEI) grafted Silica nanoparticles and their application for textile wastewater treatment. Environ. Technol. 2022, 1–17. [Google Scholar] [CrossRef] [PubMed]
- Abbas, T.K.; Rashid, K.T.; Alsalhy, Q.F. NaY zeolite-polyethersulfone-modified membranes for the removal of cesium-137 from liquid radioactive waste. Chem. Eng. Res. Des. 2022, 179, 535–548. [Google Scholar] [CrossRef]
- Nasrollahi, N.; Aber, S.; Vatanpour, V.; Mahmoodi, N.M. The effect of amine functionalization of CuO and ZnO nanoparticles used as additives on the morphology and the permeation properties of polyethersulfone ultrafiltration nanocomposite membranes. Compos. Part B Eng. 2018, 154, 388–409. [Google Scholar] [CrossRef]
- Arumugham, T.; Amimodu, R.G.; Kaleekkal, N.J.; Rana, D. Nano CuO/g-C3N4 sheets-based ultrafiltration membrane with enhanced interfacial affinity, antifouling and protein separation performances for water treatment application. J. Environ. Sci. 2019, 82, 57–69. [Google Scholar] [CrossRef]
- Pang, R.; Li, X.; Li, J.; Lu, Z.; Sun, X.; Wang, L. Preparation and characterization of ZrO2/PES hybrid ultrafiltration membrane with uniform ZrO2 nanoparticles. Desalination 2014, 332, 60–66. [Google Scholar] [CrossRef]
- Wen, J.; Yang, C.; Chen, X.; Qiu, M.; Fan, Y. Effective and efficient fabrication of high-flux tight ZrO2 ultrafiltration membranes using a nanocrystalline precursor. J. Membr. Sci. 2021, 634, 119378. [Google Scholar] [CrossRef]
- Maximous, N.; Nakhla, G.; Wan, W.; Wong, K. Performance of a novel ZrO2/PES membrane for wastewater filtration. J. Membr. Sci. 2010, 352, 222–230. [Google Scholar] [CrossRef]
- Zhang, Y.; Wang, L.; Xu, Y. ZrO2 solid superacid porous shell/void/TiO2 core particles (ZVT)/polyvinylidene fluoride (PVDF) composite membranes with anti-fouling performance for sewage treatment. Chem. Eng. J. 2015, 260, 258–268. [Google Scholar] [CrossRef]
- Rabiee, H.; Vatanpour, V.; Farahani, M.H.D.A.; Zarrabi, H. Improvement in flux and antifouling properties of PVC ultrafiltration membranes by incorporation of zinc oxide (ZnO) nanoparticles. Sep. Purif. Technol. 2015, 156, 299–310. [Google Scholar] [CrossRef]
- Alsalhy, Q.F.; Ali, J.M.; Abbas, A.A.; Rashed, A.; Van Der Bruggen, B.; Balta, S. Enhancement of poly(phenyl sulfone) membranes with ZnO nanoparticles. Desalination Water Treat. 2013, 51, 6070–6081. [Google Scholar] [CrossRef]
- Khorshidi, B.; Hosseini, S.A.; Ma, G.; McGregor, M.; Sadrzadeh, M. Novel nanocomposite polyethersulfone- antimony tin oxide membrane with enhanced thermal, electrical and antifouling properties. Polymer 2018, 163, 48–56. [Google Scholar] [CrossRef]
- Liu, Q.; Demirel, E.; Chen, Y.; Gong, T.; Zhang, X.; Chen, Y. Improving antifouling performance for the harvesting of Scenedesmus acuminatus using Fe 2 O 3 nanoparticles incorporated PVC nanocomposite membranes. J. Appl. Polym. Sci. 2019, 136, 47685. [Google Scholar] [CrossRef]
- Zheng, H.; Ou, J.Z.; Strano, M.S.; Kaner, R.B.; Mitchell, A.; Kalantar-Zadeh, K. Nanostructured Tungsten Oxide—Properties, Synthesis, and Applications. Adv. Funct. Mater. 2011, 21, 2175–2196. [Google Scholar] [CrossRef]
- Singh, S.; Varghese, A.M.; Reinalda, D.; Karanikolos, G.N. Graphene—Based membranes for carbon dioxide separation. J. CO2 Util. 2021, 49, 101544. [Google Scholar] [CrossRef]
- Ang, E.H.; Chew, J.W. Two-Dimensional Transition-Metal Dichalcogenide-Based Membrane for Ultrafast Solvent Permeation. Chem. Mater. 2019, 31, 10002–10007. [Google Scholar] [CrossRef]
- Ameen, A.W.; Ji, J.; Tamaddondar, M.; Moshenpour, S.; Foster, A.B.; Fan, X.; Budd, P.M.; Mattia, D.; Gorgojo, P. 2D boron nitride nanosheets in PIM-1 membranes for CO2/CH4 separation. J. Membr. Sci. 2021, 636, 119527. [Google Scholar] [CrossRef]
- Shen, Z.; Chen, W.; Xu, H.; Yang, W.; Kong, Q.; Wang, A.; Ding, M.; Shang, J. Fabrication of a Novel Antifouling Polysulfone Membrane with in Situ Embedment of Mxene Nanosheets. Int. J. Environ. Res. Public Health 2019, 16, 4659. [Google Scholar] [CrossRef] [PubMed]
- Yang, X.; Liu, Y.; Hu, S.; Yu, F.; He, Z.; Zeng, G.; Feng, Z.; Sengupta, A. Construction of Fe 3 O 4 @ MXene composite nanofiltration membrane for heavy metal ions removal from wastewater. Polym. Adv. Technol. 2020, 32, 1000–1010. [Google Scholar] [CrossRef]
- Ajibade, T.F.; Tian, H.; Lasisi, K.H.; Xue, Q.; Yao, W.; Zhang, K. Multifunctional PAN UF membrane modified with 3D-MXene/O-MWCNT nanostructures for the removal of complex oil and dyes from industrial wastewater. Sep. Purif. Technol. 2021, 275, 119135. [Google Scholar] [CrossRef]
- Sun, H.; Tang, B.; Wu, P. Development of Hybrid Ultrafiltration Membranes with Improved Water Separation Properties Using Modified Superhydrophilic Metal–Organic Framework Nanoparticles. ACS Appl. Mater. Interfaces 2017, 9, 21473–21484. [Google Scholar] [CrossRef]
- Yin, N.; Wang, K.; Wang, L.; Li, Z. Amino-functionalized MOFs combining ceramic membrane ultrafiltration for Pb (II) removal. Chem. Eng. J. 2016, 306, 619–628. [Google Scholar] [CrossRef]
- Xie, W.; Li, J.; Sun, T.; Shang, W.; Dong, W.; Li, M.; Sun, F. Hydrophilic modification and anti-fouling properties of PVDF membrane via in situ nano-particle blending. Environ. Sci. Pollut. Res. 2018, 25, 25227–25242. [Google Scholar] [CrossRef]
- Ma, J.; Guo, X.; Ying, Y.; Liu, D.; Zhong, C. Composite ultrafiltration membrane tailored by MOF@GO with highly improved water purification performance. Chem. Eng. J. 2017, 313, 890–898. [Google Scholar] [CrossRef]
- Liu, K.; Guo, J.; Li, Y.; Chen, J.; Li, P. High-Flux Ultrafiltration Membranes Combining Artificial Water Channels and Covalent Organic Frameworks. Membranes 2022, 12, 824. [Google Scholar] [CrossRef]
- Xu, W.; Sun, X.; Huang, M.; Pan, X.; Huang, X.; Zhuang, H. Novel covalent organic framework/PVDF ultrafiltration membranes with antifouling and lead removal performance. J. Environ. Manag. 2020, 269, 110758. [Google Scholar] [CrossRef]
- Zhang, Y.; Ye, H.; Chen, D.; Li, N.; Xu, Q.; Li, H.; He, J.; Lu, J. In situ assembly of a covalent organic framework composite membrane for dye separation. J. Membr. Sci. 2021, 628, 119216. [Google Scholar] [CrossRef]
- Li, X.; Fang, X.; Pang, R.; Li, J.; Sun, X.; Shen, J.; Han, W.; Wang, L. Self-assembly of TiO2 nanoparticles around the pores of PES ultrafiltration membrane for mitigating organic fouling. J. Membr. Sci. 2014, 467, 226–235. [Google Scholar] [CrossRef]
- Nayak, M.C.; Isloor, A.M.; Moslehyani, A.; Ismail, A. Preparation and characterization of PPSU membranes with BiOCl nanowafers loaded on activated charcoal for oil in water separation. J. Taiwan Inst. Chem. Eng. 2017, 77, 293–301. [Google Scholar] [CrossRef]
- Cao, X.; Ma, J.; Shi, X.; Ren, Z. Effect of TiO 2 nanoparticle size on the performance of PVDF membrane. Appl. Surf. Sci. 2006, 253, 2003–2010. [Google Scholar] [CrossRef]
- Rabiee, H.; Farahani, M.H.D.A.; Vatanpour, V. Preparation and characterization of emulsion poly(vinyl chloride) (EPVC)/TiO2 nanocomposite ultrafiltration membrane. J. Membr. Sci. 2014, 472, 185–193. [Google Scholar] [CrossRef]
- Aljanabi, A.A.A.; Mousa, N.E.; Aljumaily, M.M.; Majdi, H.S.; Yahya, A.A.; Al-Baiati, M.N.; Hashim, N.; Rashid, K.T.; Al-Saadi, S.; Alsalhy, Q.F. Modification of Polyethersulfone Ultrafiltration Membrane Using Poly(terephthalic acid-co-glycerol-g-maleic anhydride) as Novel Pore Former. Polymers 2022, 14, 3408. [Google Scholar] [CrossRef]
- Ali, A.; Rashid, K.; Yahya, A.; Majdi, H.; Salih, I.; Yusoh, K.; Alsalhy, Q.; AbdulRazak, A.; Figoli, A. Fabrication of Gum Arabic-Graphene (GGA) Modified Polyphenylsulfone (PPSU) Mixed Matrix Membranes: A Systematic Evaluation Study for Ultrafiltration (UF) Applications. Membranes 2021, 11, 542. [Google Scholar] [CrossRef]
- Bardajee, G.R.; Hosseini, S.S.; Vancaeyzeele, C. Graphene oxide nanocomposite hydrogel based on poly(acrylic acid) grafted onto salep: An adsorbent for the removal of noxious dyes from water. New J. Chem. 2019, 43, 3572–3582. [Google Scholar] [CrossRef]
- Joshi, R.K.; Alwarappan, S.; Yoshimura, M.; Sahajwalla, V.; Nishina, Y. Graphene oxide: The new membrane material. Appl. Mater. Today 2015, 1, 1–12. [Google Scholar] [CrossRef]
- Hegab, H.M.; Zou, L. Graphene oxide-assisted membranes: Fabrication and potential applications in desalination and water purification. J. Membr. Sci. 2015, 484, 95–106. [Google Scholar] [CrossRef]
- Zhang, X.; Xu, Z.; Wang, L.; Wang, X.; Zeng, Y.; Zhang, G. Graphene-Based Ultrafiltration Membranes for Separation: Synthesis and Applications. Recent Pat. Eng. 2018, 12, 37–45. [Google Scholar] [CrossRef]
- Zhu, Y.; Murali, S.; Cai, W.; Li, X.; Suk, J.W.; Potts, J.R.; Ruoff, R.S. Graphene and Graphene Oxide: Synthesis, Properties, and Applications. Adv. Mater. 2010, 22, 3906–3924. [Google Scholar] [CrossRef] [PubMed]
- Yang, J.; Tian, C.; Wang, L.; Tan, T.; Yin, J.; Wang, B.; Fu, H. In Situ Reduction, Oxygen Etching, and Reduction Using Formic Acid: An Effective Strategy for Controllable Growth of Monodisperse Palladium Nanoparticles on Graphene. ChemPlusChem 2012, 77, 301–307. [Google Scholar] [CrossRef]
- Ng, L.Y.; Chua, H.S.; Ng, C.Y. Incorporation of graphene oxide-based nanocomposite in the polymeric membrane for water and wastewater treatment: A review on recent development. J. Environ. Chem. Eng. 2021, 9, 105994. Available online: https://www.sciencedirect.com/science/article/pii/S2213343721009714 (accessed on 2 November 2021). [CrossRef]
- Mahalingam, D.K.; Kim, D.; Nunes, S.P. Polyethersulfone/Graphene Oxide Ultrafiltration Membranes from Solutions in Ionic Liquid. MRS Adv. 2017, 46, 2505–2511. [Google Scholar] [CrossRef]
- Kazemi, F.; Jafarzadeh, Y.; Masoumi, S.; Rostamizadeh, M. Oil-in-water emulsion separation by PVC membranes embedded with GO-ZnO nanoparticles. J. Environ. Chem. Eng. 2020, 9, 104992. [Google Scholar] [CrossRef]
- Chang, X.; Wang, Z.; Quan, S.; Xu, Y.; Jiang, Z.; Shao, L. Exploring the synergetic effects of graphene oxide (GO) and polyvinylpyrrodione (PVP) on poly(vinylylidenefluoride) (PVDF) ultrafiltration membrane performance. Appl. Surf. Sci. 2014, 316, 537–548. [Google Scholar] [CrossRef]
- Xiao, S.; Yu, S.; Yan, L.; Liu, Y.; Tan, X. Preparation and properties of PPSU/GO mixed matrix membrane. Chin. J. Chem. Eng. 2017, 25, 408–414. [Google Scholar] [CrossRef]
- Yadav, S.; Ibrar, I.; Samal, A.K.; Altaee, A.; Déon, S.; Zhou, J.; Ghaffour, N. Preparation of fouling resistant and highly perm-selective novel PSf/GO-vanillin nanofiltration membrane for efficient water purification. J. Hazard. Mater. 2021, 421, 126744. [Google Scholar] [CrossRef]
- Ravishankar, H.; Christy, J.; Jegatheesan, V. Graphene Oxide (GO)-Blended Polysulfone (PSf) Ultrafiltration Membranes for Lead Ion Rejection. Membranes 2018, 8, 77. [Google Scholar] [CrossRef]
- Awad, E.; Sabirova, T.; Tretyakova, N.; Alsalhy, Q.; Figoli, A.; Salih, I. A Mini-Review of Enhancing Ultrafiltration Membranes (UF) for Wastewater Treatment: Performance and Stability. ChemEngineering 2021, 5, 34. [Google Scholar] [CrossRef]
- Wu, H.; Tang, B.; Wu, P. Development of novel SiO2–GO nanohybrid/polysulfone membrane with enhanced performance. J. Membr. Sci. 2014, 451, 94–102. [Google Scholar] [CrossRef]
- Raikwar, S.; Prajapati, Y.K.; Srivastava, D.K.; Saini, J.P. Graphene oxide based SPR sensor for sensing of sea water concentration. Results Opt. 2020, 1, 100011. [Google Scholar] [CrossRef]
- Ali, F.A.A.; Alam, J.; Shukla, A.K.; Alhoshan, M.; Ansari, M.A.; Al-Masry, W.A.; Rehman, S.; Alam, M. Evaluation of antibacterial and antifouling properties of silver-loaded GO polysulfone nanocomposite membrane against Escherichia coli, Staphylococcus aureus, and BSA protein. React. Funct. Polym. 2019, 140, 136–147. [Google Scholar] [CrossRef]
- Alias, S.S.; Harun, Z.; Azhar, F.H.; Yusof, K.N.; Jamalludin, M.R.; Hubadillah, S.K.; Basri, S.N.; Al-Harthi, M.A. Enhancing the performance of a hybrid porous polysulfone membrane impregnated with green Ag/AgO additives derived from the Parkia speciosa. Vacuum 2019, 163, 301–311. [Google Scholar] [CrossRef]
- Li, C.; Sun, W.; Lu, Z.; Ao, X.; Yang, C.; Li, S. Systematic evaluation of TiO2-GO-modified ceramic membranes for water treatment: Retention properties and fouling mechanisms. Chem. Eng. J. 2019, 378, 122138. [Google Scholar] [CrossRef]
- Behboudi, A.; Jafarzadeh, Y.; Yegani, R. Preparation and characterization of TiO2 embedded PVC ultrafiltration membranes. Chem. Eng. Res. Des. 2016, 114, 96–107. [Google Scholar] [CrossRef]
- Khakpour, S.; Jafarzadeh, Y.; Yegani, R. Incorporation of graphene oxide/nanodiamond nanocomposite into PVC ultrafiltration membranes. Chem. Eng. Res. Des. 2019, 152, 60–70. [Google Scholar] [CrossRef]
- Wu, L.-G.; Zhang, X.-Y.; Wang, T.; Du, C.-H.; Yang, C.-H. Enhanced performance of polyvinylidene fluoride ultrafiltration membranes by incorporating TiO2/graphene oxide. Chem. Eng. Res. Des. 2018, 141, 492–501. [Google Scholar] [CrossRef]
- Manikandan, G.N.; Kalavathy, H. Performance studies of GO/PF127 incorporated Polyetherimide Ultrafiltration membranes for the rejection of oil from oil wastewater. Chem. Eng. Res. Des. 2021, 168, 214–226. [Google Scholar] [CrossRef]
- Liu, Y.; Zhu, M.; Chen, M.; Ma, L.; Yang, B.; Li, L.; Tu, W. A polydopamine-modified reduced graphene oxide (RGO)/MOFs nanocomposite with fast rejection capacity for organic dye. Chem. Eng. J. 2019, 359, 47–57. [Google Scholar] [CrossRef]
- Noamani, S.; Niroomand, S.; Rastgar, M.; Sadrzadeh, M. Carbon-based polymer nanocomposite membranes for oily wastewater treatment. NPJ Clean Water 2019, 2, 20. [Google Scholar] [CrossRef]
- Wang, W.; Zhu, L.; Shan, B.; Xie, C.; Liu, C.; Cui, F.; Li, G. Preparation and characterization of SLS-CNT/PES ultrafiltration membrane with antifouling and antibacterial properties. J. Membr. Sci. 2018, 548, 459–469. [Google Scholar] [CrossRef]
- Liu, H.; Cao, C.-Y.; Wei, F.-F.; Huang, P.-P.; Sun, Y.-B.; Jiang, L.; Song, W.-G. Flexible macroporous carbon nanofiber film with high oil adsorption capacity. J. Mater. Chem. A 2013, 2, 3557–3562. [Google Scholar] [CrossRef]
- Vani, B.; Shivakumar, M.; Kalyani, S.; Sridhar, S. TiO2 nanoparticles incorporated high-performance polyphenyl sulfone mixed matrix membranes for ultrafiltration of domestic greywater. Iran. Polym. J. 2021, 30, 917–934. [Google Scholar] [CrossRef]
- Zinadini, S.; Zinatizadeh, A.A.; Rahimi, M.; Vatanpour, V.; Zangeneh, H. Preparation of a novel antifouling mixed matrix PES membrane by embedding graphene oxide nanoplates. J. Membr. Sci. 2014, 453, 292–301. [Google Scholar] [CrossRef]
- Li, X.; Li, J.; Van der Bruggen, B.; Sun, X.; Shen, J.; Han, W.; Wang, L. Fouling behavior of polyethersulfone ultrafiltration membranes functionalized with sol–gel formed ZnO nanoparticles. RSC Adv. 2015, 5, 50711–50719. [Google Scholar] [CrossRef]
- Sotto, A.; Boromand, A.; Zhang, R.; Luis, P.; Arsuaga, J.M.; Kim, J.; Van der Bruggen, B. Effect of nanoparticle aggregation at low concentrations of TiO2 on the hydrophilicity, morphology, and fouling resistance of PES–TiO2 membranes. J. Colloid Interface Sci. 2011, 363, 540–550. [Google Scholar] [CrossRef]
- Zhao, Y.; Lu, J.; Liu, X.; Wang, Y.; Lin, J.; Peng, N.; Li, J.; Zhao, F. Performance enhancement of polyvinyl chloride ultrafiltration membrane modified with graphene oxide. J. Colloid Interface Sci. 2016, 480, 1–8. [Google Scholar] [CrossRef]
- Al-sultan, A.A.; Khadim, R.J.; Al-emami, O.H.; Alsalhy, Q.F.; Majdi, H.S. Optimization of Graphene Oxide Mixed Matrix Membrane for AB-210 Dye Removal. J. Ecol. Eng. 2022, 23, 115–127. [Google Scholar] [CrossRef]
- Al-Araji, D.D.; Al-Ani, F.H.; Alsalhy, Q.F. The permeation and Separation Characteristics of Polymeric Membranes Incorporated with Nanoparticles for Dye Removal and Interaction Mechanisms between Polymer and Nanoparticles: A Mini Review. Eng. Technol. J. 2022, 40, 1–13. [Google Scholar] [CrossRef]
- Igbinigun, E.; Fennell, Y.; Malaisamy, R.; Jones, K.L.; Morris, V. Graphene oxide functionalized polyethersulfone membrane to reduce organic fouling. J. Membr. Sci. 2016, 514, 518–526. [Google Scholar] [CrossRef]
- Wasim, M.; Sabir, A.; Khan, R.U. Membranes with tunable graphene morphology prepared via Stöber method for high rejection of azo dyes. J. Environ. Chem. Eng. 2021, 9, 106069. [Google Scholar] [CrossRef]
- Abdullah, R.R.; Shabeeb, K.M.; Alzubaydi, A.B.; Figoli, A.; Criscuoli, A.; Drioli, E.; Alsalhy, Q. Characterization of the Efficiency of Photo-Catalytic Ultrafiltation PES Membrane Modified with Tungsten Oxide in the Removal of Tinzaparin Sodium. Eng. Technol. J. 2022, 40, 1–10. [Google Scholar] [CrossRef]
- Kahkahni, R.; Patel, R.; Kim, J.H. Photocatalytic Membrane for Contaminants Degradation: A Review. Membr. J. 2022, 32, 33–42. [Google Scholar] [CrossRef]
- Zhang, L.; Shi, X.; Sun, M.; Porter, C.J.; Zhou, X.; Elimelech, M. Precisely Engineered Photoreactive Titanium Nanoarray Coating to Mitigate Biofouling in Ultrafiltration. ACS Appl. Mater. Interfaces 2021, 13, 9975–9984. [Google Scholar] [CrossRef]
- Xu, Z.; Ye, S.; Zhang, G.; Li, W.; Gao, C.; Shen, C.; Meng, Q. Antimicrobial polysulfone blended ultrafiltration membranes prepared with Ag/Cu2O hybrid nanowires. J. Membr. Sci. 2016, 509, 83–93. [Google Scholar] [CrossRef]

| Fouling Mechanisms | V-t Equation | J-t Equation |
|---|---|---|
| Complete pore blocking | ||
| Standard pore blocking | ||
| Intermediate pore blocking | ||
| Cake filtration |
| Type of Polymer | Composition of Pure GO | %Porosity | Pore Size (nm) | Thickness (μm) | Tensile Strength (Mpa) | Contact Angle | Flux (L/m2·h) | Rejection (%) | Ref. |
|---|---|---|---|---|---|---|---|---|---|
| PES | PES–PVP–0.5 GO | 80.6% | 14.59 | 150.13 | 2.55 | 39.21 | 116.5 LMH bar | 99.7% Acid Black dye | [30] |
| PVC | PVC/GO (0.05) | 55 | 2.86 | 75.51 | 1526.71 L/m2·h | 96.62% Oil | [106] | ||
| PVDF | PVDF/GO-PVP | 68 | 104.3 L/m2·h | 85% BSA | [107] | ||||
| PPSU | 1.5 wt% GO | 63.7% | 30.1 | 67.1 | 231.7 L/m2·h | 95% BAS | [108] | ||
| PSF | 200 mg GO | 56% | 10.58 | 101 | 50.31 | 91 L/m2·h | 92.5% MgSO4 | [109] | |
| PSF | 1% wt GO | 82.23% | 22.73 | 1.1 | 34.2 | 163.71 L/m2·h | 25.4% NaCl | [110] |
| Type of Polymer | Composition of GO–Inorganic NPs | Porosity (%) | Pore Size (nm) | Tensile Strength (Mpa) | Contact Angle | Flux (L/m2·h) | Rejection (%) | Ref. |
|---|---|---|---|---|---|---|---|---|
| PVC | PVC-0.119 wt.% MWCNTs-g-GO | 81.4 | 259 | 1.4 | 13.9 | 254 L/m2·h | 88.9% Oil | [48] |
| PVC | PVC/GO-ZnO (0.05) | 25 | 3.49 | 68.78 | 1255.14 L/m2·h | 99.55% Oil | [106] | |
| PVC | PVC/GO-ND 0.1)) | 350 | 5 | 64.6 | 425 L/m2·h | 95.08% BSA | [118] | |
| PVDF | PVDF/TiO2–GO | 43 | 50 | 67 | 199.97 L/m2·h | 91.38% BSA | [119] | |
| PEI | PEI/PF-127/GO (0.6 wt%) | 76.8 | 28.23 | 5.9 | 46.8 | 325 L/m2·h | 95% Oil | [120] |
| PDA | PDA/RGO/HKUST-1 | 32.1 | 184.7 L/m2·h | 99.8% dye | [121] | |||
| PSF | SiO2-GO/PSF | 2.3 | 63 | 360 L/m2·h | 98.3% BSA | [112] |
Publisher’s Note: MDPI stays neutral with regard to jurisdictional claims in published maps and institutional affiliations. |
© 2022 by the authors. Licensee MDPI, Basel, Switzerland. This article is an open access article distributed under the terms and conditions of the Creative Commons Attribution (CC BY) license (https://creativecommons.org/licenses/by/4.0/).
Share and Cite
Al-Maliki, R.M.; Alsalhy, Q.F.; Al-Jubouri, S.; Salih, I.K.; AbdulRazak, A.A.; Shehab, M.A.; Németh, Z.; Hernadi, K. Classification of Nanomaterials and the Effect of Graphene Oxide (GO) and Recently Developed Nanoparticles on the Ultrafiltration Membrane and Their Applications: A Review. Membranes 2022, 12, 1043. https://doi.org/10.3390/membranes12111043
Al-Maliki RM, Alsalhy QF, Al-Jubouri S, Salih IK, AbdulRazak AA, Shehab MA, Németh Z, Hernadi K. Classification of Nanomaterials and the Effect of Graphene Oxide (GO) and Recently Developed Nanoparticles on the Ultrafiltration Membrane and Their Applications: A Review. Membranes. 2022; 12(11):1043. https://doi.org/10.3390/membranes12111043
Chicago/Turabian StyleAl-Maliki, Raghad M., Qusay F. Alsalhy, Sama Al-Jubouri, Issam K. Salih, Adnan A. AbdulRazak, Mohammed Ahmed Shehab, Zoltán Németh, and Klara Hernadi. 2022. "Classification of Nanomaterials and the Effect of Graphene Oxide (GO) and Recently Developed Nanoparticles on the Ultrafiltration Membrane and Their Applications: A Review" Membranes 12, no. 11: 1043. https://doi.org/10.3390/membranes12111043
APA StyleAl-Maliki, R. M., Alsalhy, Q. F., Al-Jubouri, S., Salih, I. K., AbdulRazak, A. A., Shehab, M. A., Németh, Z., & Hernadi, K. (2022). Classification of Nanomaterials and the Effect of Graphene Oxide (GO) and Recently Developed Nanoparticles on the Ultrafiltration Membrane and Their Applications: A Review. Membranes, 12(11), 1043. https://doi.org/10.3390/membranes12111043

